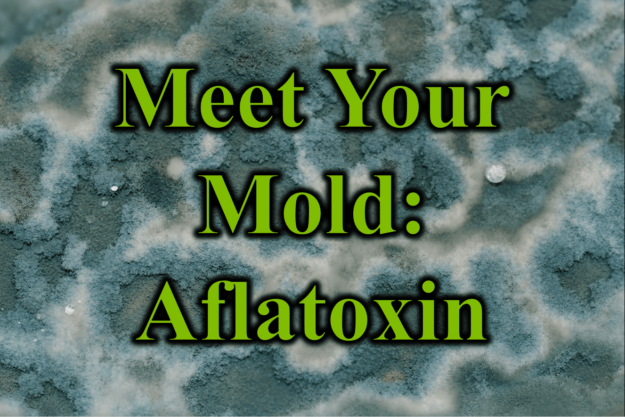
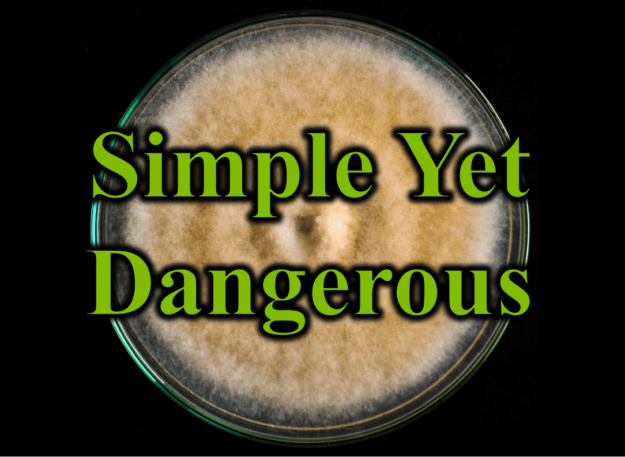

Rewriting Mold: Introducing CIRS
For those not aware of our Mold Symptom Therapy Guide website, let this “Rewriting Mold” series serve as a reminder of both what we offer our patients and what we offer the general public in terms of understanding mold toxicity illness. Over the coming weeks, I will be reviewing and reposting sections of our Mold…